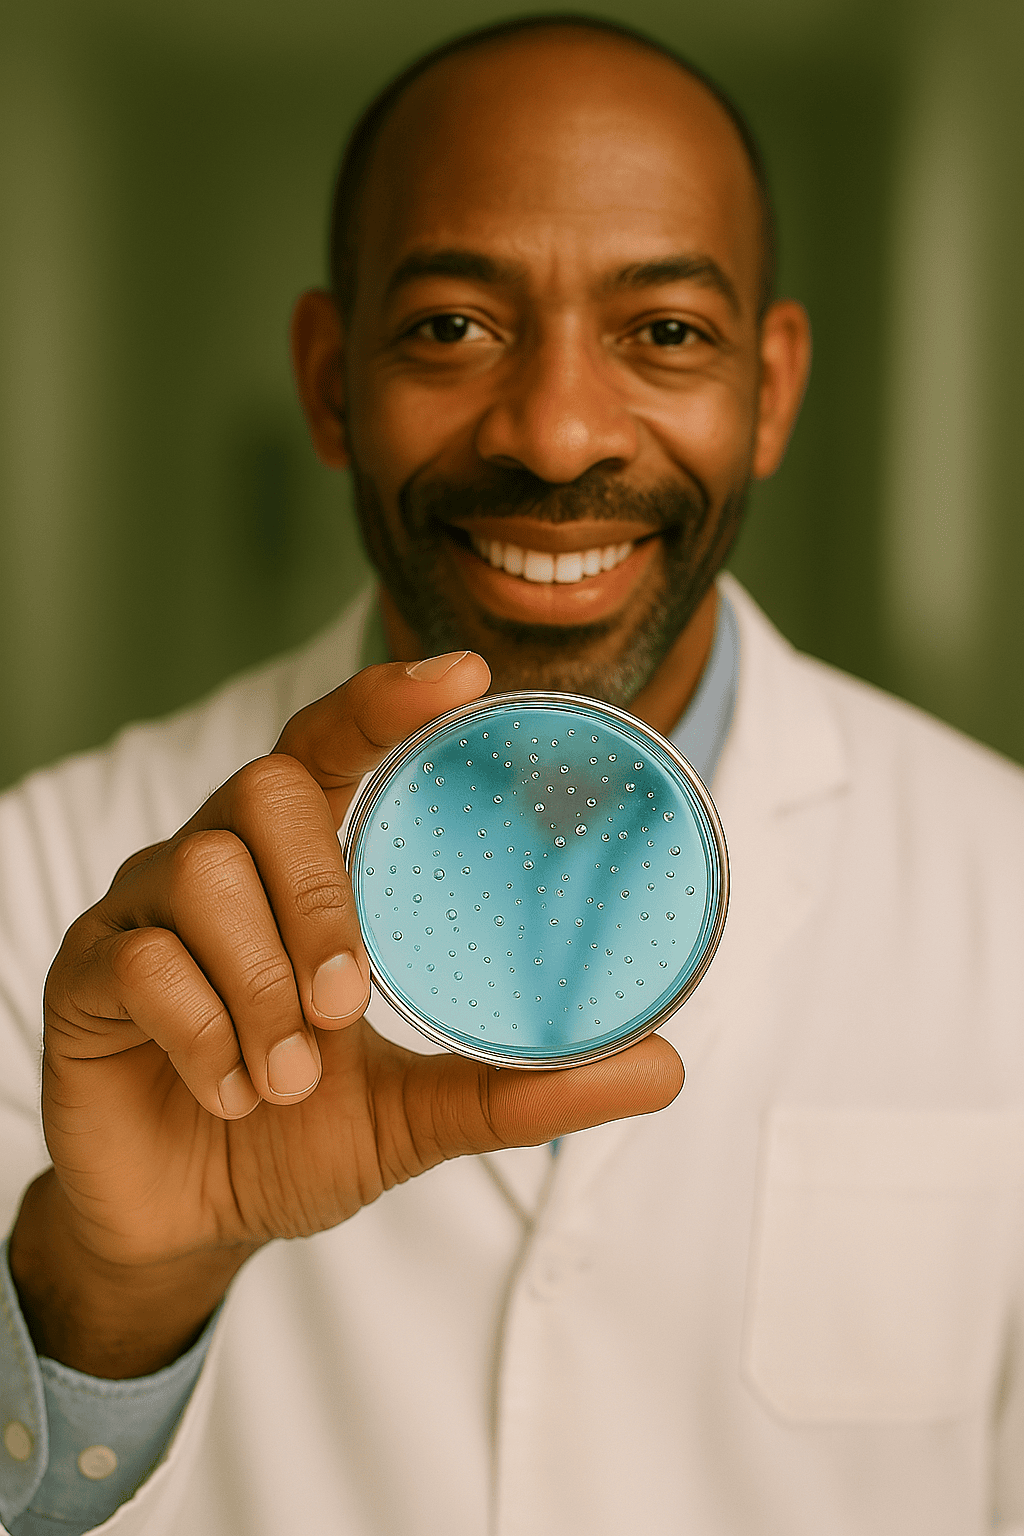

Suas lentes EyEx

Conheça nossas marcas!

PRO-x

Plus

Advance

Drive Full HD

SportX

Work's

Easy HD

VS ID Full
Nossos tratamentos

OptiBalance
You can edit text on your website by double clicking on a text box on your website. Alternatively, when you select a text box a settings menu will appear. your website by double clicking on a text box on your website. Alternatively, when you select a text box

Clarity Blue
You can edit text on your website by double clicking on a text box on your website. Alternatively, when you select a text box a settings menu will appear. your website by double clicking on a text box on your website. Alternatively, when you select a text box
HYDRO-x Blue
You can edit text on your website by double clicking on a text box on your website. Alternatively, when you select a text box a settings menu will appear. your website by double clicking on a text box on your website. Alternatively, when you select a text box

